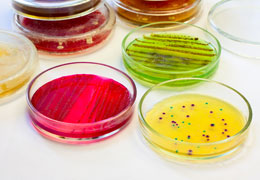

Респираторы помогают защититься от вирусной инфекции, но насколько они эффективны? Стоит ли выбирать полностью закрытые средства защиты, или можно без опасений пользоваться респираторами с клапаном? Ученые установили, насколько эффективны маски на самом деле.
Хорошую защиту от COVID-19 обеспечивают специальные медицинские респираторы с правильно подобранным антивирусным картриджем. Они плотно прилегают к нижней части лица, позволяя воздуху проникать только через фильтр. Такие респираторы используют врачи, которые контактируют с больными новой коронавирусной инфекцией.
Привет!!!
Предоставление спонсорской помощи ГУ «Червенский дом-интернат для детей-инвалидов с особенностями психофизического развития» в количестве 94шт.
3 октября 2019 года был проведён семинар в рамках презентации «Современное весовое оборудование, анализаторы влажности и анализаторы вязкости AND» для руководителей, начальников (заведующих), сотрудников химических, микробиологических, эколого-аналитических, научно-исследовательских, нефтехимических и других лабораторий.
"Жидкое мыло" не только бережно моет и очищает кожу, но и смягчает ее, тонизирует благодаря содержанию натуральных растительных экстрактов. Насыщенные фруктовые ароматы придают коже благоухание и чувство летней свежести. Фасовка в ПЭТ бутылки 5кг-выгодное экономическое решение: идеальна для заправки дозаторов и использование емкостей меньшего размера.
Где купить лабораторное оборудование?
28 августа в Минске прошёл специализированный семинар на тему: «Лабораторное оборудование, ГСО, Лабораторная мебель, посуда и изделия из пластмассы». Организатором и учредителем семинара выступила наша компания «Высокий город».
Все понимают, насколько важна в человеческой жизни вода. Дело в том, что эта волшебная жидкость не только доставляет всевозможные питательные вещества, микроэлементы и кислород клеткам организма, но и является самым главным элементом в процессе терморегуляции. Функции очистки человеческого организма практически полностью выполняет вода. Вода настолько важна в процессе нашей жизнедеятельности, что без нее мы просто не сможем прожить. Итак, мы уже поняли, насколько вода актуальна. Теперь стоит поговорить о том, какую жидкость мы употребляем и чем это может нам грозить.
Ни один вид научно-исследовательской или аналитической работы, связанной с проведением химических опытов, невозможно представить без использования химических реактивов. Основная область применения химреактивов – проведение различных лабораторных исследований. Однако реактивы высокой степени чистоты нередко бывают востребованы и в промышленных целях. Чаще всего химреактивы являются веществами индивидуального состава, но иногда они могут встречаться в качестве смесей и различных соединений. Используются химические реактивы в жидком, твердом или газообразном состояниях.
Значимость питательных сред переоценить весьма сложно. Основная их область применения – это дифференциация различных недугов, связанных с инфекционными заболеваниями, изготовление вакцин и антибиотиков. Питательные среды активно используются в медицинских и микробиологических исследованиях, фармацевтической промышленности.
Приготовление питательных сред – специфический процесс, который должен следовать установленной методике и процедурам. Для качественного культивирования питательных сред чрезвычайно важно придерживаться определенной последовательности действий.